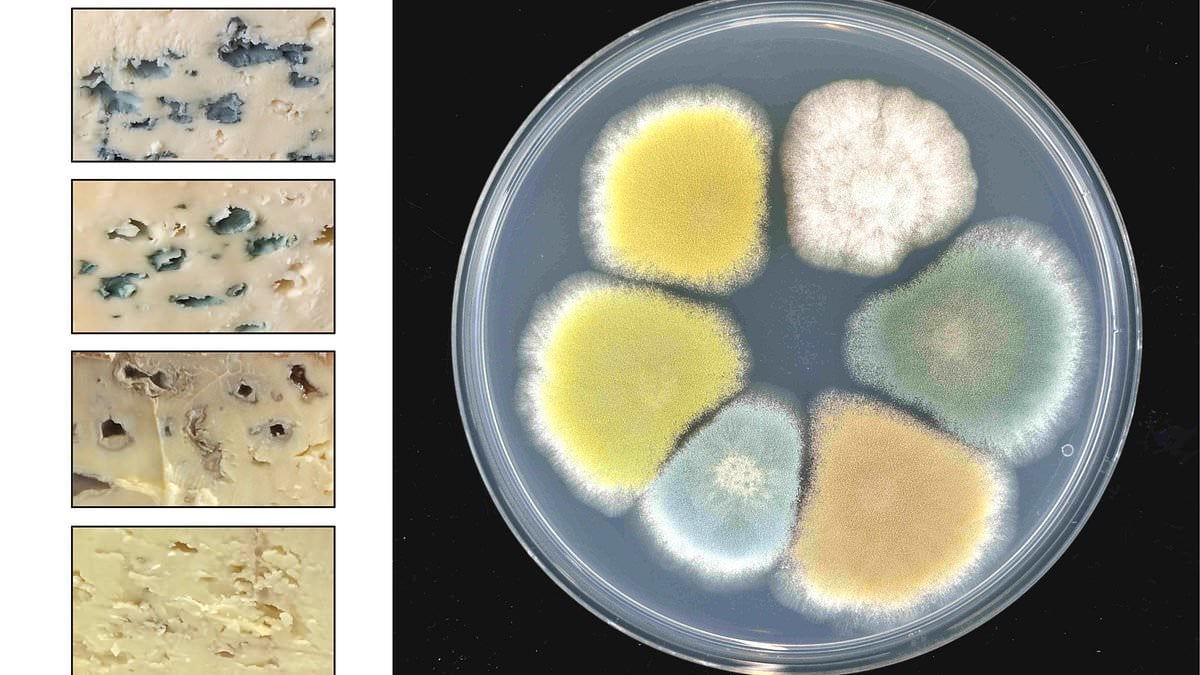
Featured image for "Cheesy Breakthrough: Scientists Expand Blue Cheese Palette with Vibrant New Colors"

The Hidden Benefits of Adding Salt When Boiling Eggs
Adding salt to boiling water for eggs doesn't make peeling easier but helps prevent egg whites from leaking out if the shell cracks, by speeding up protein coagulation and forming a protective seal, according to recent scientific research. The real factors influencing peelability are egg age, cooking method, and immediate cooling, not salt. Salt's role is primarily as a safeguard during cooking, not a shortcut for peeling.